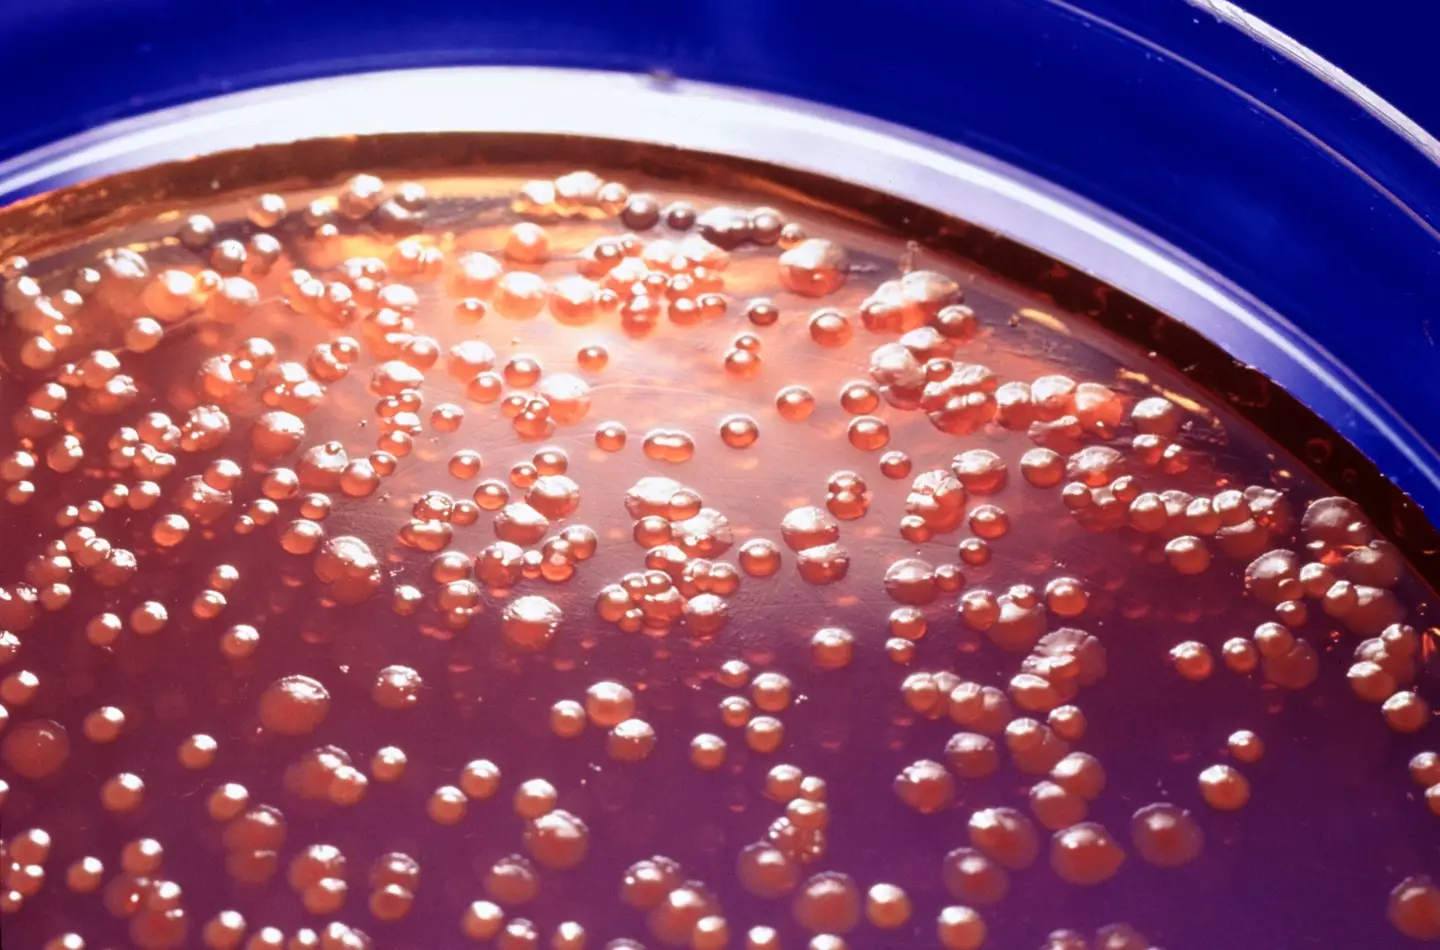

Scientists have made the rather startling discovery of deadly 'vampire' bacteria that researchers say are constantly on the hunt to feed on human blood.
The grim find, discovered by a team in the United States, is enough to send shivers down your spine.
And sadly it's not a late April Fools but entirely real.
Washington State University researchers have delved in to the topic, looking at what drives some of the most deadly bacteria in the world.
Advert
Their results are something out of a horror film, with it stating that the bacteria is actually attracted to the liquid part of blood, called serum.
In particular, the deadly germs are obsessed with something called serine, which is an amino acid in human blood.
It's also incredibly common in protein drinks, so if you're a gym bunny, run for the hills.
The work has been published in the journal eLife, which looks at providing new insights in to how bloodstream infections occur and could be potentially treated.
Advert

Arden Baylink, a professor at WSU’s College of Veterinary Medicine and corresponding author for the research, said: "Bacteria infecting the bloodstream can be lethal.
"We learned some of the bacteria that most commonly cause bloodstream infections actually sense a chemical in human blood and swim toward it."
Baylink and his colleagues found that at least three types of grim bacteria are attracted to serum in human blood; Salmonella enterica, E. coli and Citrobacter koseri.
Advert
Sadly these germs kill and are among the biggest killers for people with inflammatory bowel diseases (IBD), with intestinal bleeding common.

A high-powered microscope system used by the researchers simulated intestinal bleeding by injecting microscopic amounts of human serum and watching as the bacteria navigated toward the source. The response is extremely quick, with the work finding that it takes less than a minute for the disease-causing bacteria to find the serum.
WSU Ph.D. student Siena Glenn, lead author on the study, said: "By learning how these bacteria are able to detect sources of blood, in the future we could develop new drugs that block this ability.
Advert
"These medicines could improve the lives and health of people with IBD who are at high risk for bloodstream infections."
Scientists Zealon Gentry-Lear, Michael Shavlik, and Michael Harms of the University of Oregon, and Tom Asaki, a mathematician at WSU, contributed to the research.
The study was funded by WSU and the National Institute of Allergy and Infectious Diseases.
Topics: Education, Health, Science, US News, World News